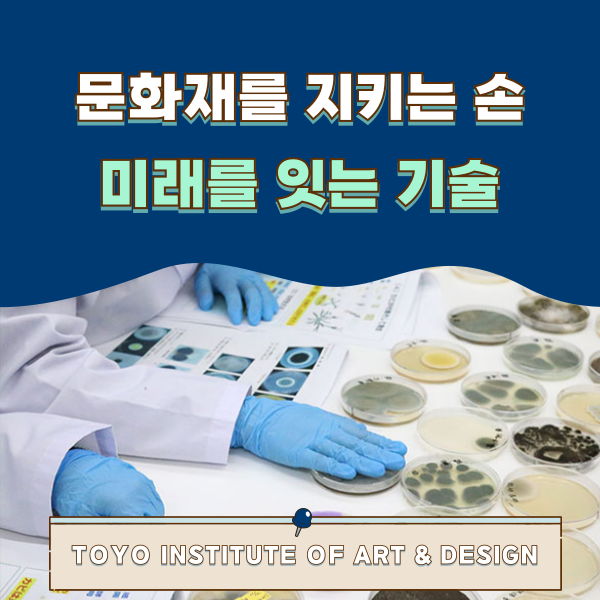
동양미술학교 문화재 보존수복과 1.png

동양미술학교 |
동양미술학교 보존수복과 문화재를 살리는 기술 수업
작성일 2025-11-14
본문
고요한 실습실,
붓끝이 미세한 균열을 살짝 시치고
그 아래에 남아 있는 '기억'을 찾듯
손이 천천히 움직여요.
동양미술학교 보존수복과에서는
단순히 '고친다'가 아니라,
작품에 깃든 시간과 사람들의 마음을
미래로 이어가는 기술과 정신을 배워요.
미술을 '창작'하는 것뿐 아니라,
'남긴다'라는 또 하나의 아름다움과 마주하는 일
이곳엔 그 길을 향한 탄탄한 배움이 있어요.
보존수복과 졸생들은
박물관, 미술관, 문화재 복원 회사 등
실제 현장에서 폭넓게 활약하고 있어요.
그중에서도 유화 수복 분야에서 주목받는
아오야마 리오 씨는
동양미술학교 졸업 후 대학원에서 공부를 이어가며
노후화가 진행된
'카라스즈 신사' 재생 프로젝트에 참여했어요.
'문화재를 지킨다는 건, 물건을 고치는 게 아니라
그 안에 담긴 사람들의 기억을 남기는 일이에요.'
그의 말 속에는 동양미술학교에서 배운
세심하게 보고, 정성스레 손을 움직이는 태도가
그대로 살아 있어요.
동양미술학교는 재학 중부터 실전 경험이 풍부해요.
현재 히비야 도서문화관에서 진행 중인
'100년 후에도 손에 들 수 있는 책을,
내전 가키치 문고 수복 보고전2025'에서는
보존수복과 학생들이 수업에서 제작한
서적 수복 작품이 전시되고 있어요.
또한 4년 동안 6개 분야의
수복 기술을 체계적으로 배우고,
만화 원화 보존 프로젝트, 재난 자료 구조 활동 등
사회와 연결된 실습 경험 역시 쌓을 수 있어요.
보존수복과에서는 회화, 조각, 종이자료,
가구, 건축 부재 등
다양한 소재를 다루며 이론과 실습을
단계적으로 익혀요.
1학년
보존수복의 기초 이론 및 기본 기술
2학년
다양한 실습으로 도구, 재료, 기술에 대한 이해
3학년
각 분야의 보존수복 작업을 경험
4학년
4년간의 정리와 장래 결정
→ 결과물은 졸업전에서 발표
실제 문화재를 다루는 실습에서는
붓, 헤라, 접착제 냄새가 어우러진 교실에서
학생들이 변화 하나하나를 기록하며 작품과 마주해요.
'보이지 않는 부분까지 정성스럽게'
이것이 동양미술학교가
가장 중요하게 여기는 정신이에요.
교내에는 수복 실습실, 갤러리관, 단계연 전시 등
실기 중심의 환경이 충분히 갖춰져 있어요.
유학생 지원도 활발해
전문용어 일본어 수업,
문화적 배경 이해 수업 등이 운영되어
일본어로 배우는 것이 처음인 학생도
안심하고 시작할 수 있어요.
졸업 후의 진로는 다양해요.
✔ 일본 내 문화재 보존, 미술 분야 취업
✔ 모국에서 문화유산 보호 분야로 진출
✔ 일본의 기술을 세계로 전하는 전문가로 활동
또한 '고도전문사' 취득이 가능해요.
학예사 자격 취득을 목표로 할 수도 있어요.
문화재 수복은 지금의 아름다움을 위한 일이 아니라,
미래의 누군가가 다시 만날 가치를 지키는 일이에요.
'진짜 문화재를 직접 다루며 배우고 싶다'
'문화유산을 지키는 일을 내 진로로 삼고 싶다'
그렇다면 보존수복과에서의 배움은
여러분의 확실한 첫걸음이 될 거예요.
손으로, 관찰로, 그리고 마음으로
문화를 미래에 있는 배움.
동양미술학교에는 환경과 기회가
모두 준비되어 있어요.
창작만이 미술의 전부가 아니에요.
'남기는 미술'이라는 새로운 아름다움을 만나보세요!
오픈캠퍼스에서 그 첫 경험을
직접 확인해보길 바래요!
학교를 체험할 수 있는 기회,
매달 원하는 일정을 선택하여
무료로 수업을 참여할 수 있어요
*예약이 필요합니다.
https://www.to-bi.ac.jp/dept/cdc/